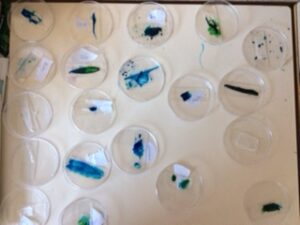

La setmana passada vam fer un experiment per observar com són les cèl·lules de la ceba.
Per fer aquest experiment vam necessitar: una ceba, un portaobjectes, una càpsula de petri, unes pinces i una tinta de color (voluntari).
Experiment:
Vam agafar un tros de pell de la ceba amb les pinces i la vam posar al portaobjectes. Després, si volíem, podíem posar tinta de color perquè es veiés millor pel microscopi.
Al final, vam mirar pel microscopi i vam veure un conjunt de cèl·lules que semblaven un rusc d’abelles.
Va ser prou interessant arribar a veure aquestes cèl·lules de la ceba!!!
Alumnes de 6è.